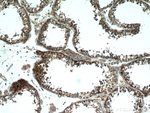
PDXDC1 Antibody in Immunohistochemistry (Paraffin) (IHC (P))

Search
Proteintech
PDXDC1 Polyclonal Antibody
{{$productOrderCtrl.translations['antibody.pdp.commerceCard.promotion.promotions']}}
{{$productOrderCtrl.translations['antibody.pdp.commerceCard.promotion.viewpromo']}}
{{$productOrderCtrl.translations['antibody.pdp.commerceCard.promotion.promocode']}}: {{promo.promoCode}} {{promo.promoTitle}} {{promo.promoDescription}}. {{$productOrderCtrl.translations['antibody.pdp.commerceCard.promotion.learnmore']}}

Please note: We are reviewing Western blot images included in the antibody testing data in our catalog, including those provided by third parties. Unless expressly labeled or annotated as “raw-unedited”, Western blot images included in the antibody testing data in our catalog may have been edited, optimized or otherwise adjusted for presentation.
产品信息
21021-1-AP
种属反应
宿主/亚型
分类
类型
抗原
偶联物
形式
浓度
规格
纯化类型
保存液
内含物
保存条件
运输条件
产品详细信息
Immunogen sequence: MDASLEKIA DPTLAEMGKN LKEAVKMLED SQRRTEEENG KKLISGDIPG PLQGSGQDMV SILQLVQNLM HGDEDEEPQS PRIQNIGEQG HMALLGHSLG AYISTLDKEK LRKLTTRILS DTTLWLCRIF RYENGCAYFH EEEREGLAKI CRLAIHSRYE DFVVDGFNVL YNKKPVIYLS AAARPGLGQY LCNQDVAFLE KLIKDDIERG RLPLLLVANA GTAAVGHTDK IGRLKELCEQ YGIWLHVEGV NLATLALGYV SSSVLAAAKC DSMTMTPGPW LGLPAVPAVT LYKHDDPALT LVAGLTSNKP TDKLRALPLW LSLQYLGLDG FVERIKHACQ LSQRLQ (1-345 aa encoded by B C033748)
靶标信息
PDXDC1 (Pyridoxal Dependent Decarboxylase Domain Containing 1) is a Protein Coding gene. Diseases associated with PDXDC1 include Autosomal Recessive Nonsyndromic Deafness 32 and Fetal Akinesia Deformation Sequence 1. Gene Ontology (GO) annotations related to this gene include pyridoxal phosphate binding and carboxy-lyase activity. An important paralog of this gene is HDC. [GeneCards]
仅用于科研。不用于诊断过程。未经明确授权不得转售。
生物信息学
蛋白别名: Pyridoxal-dependent decarboxylase domain-containing protein 1
基因别名: 2210010A19Rik; AA415817; KIAA0251; Kiaa0251-hp; PDXDC1; RGD1562597
UniProt ID: (Mouse) Q99K01
Entrez Gene ID: (Mouse) 94184, (Rat) 304721




